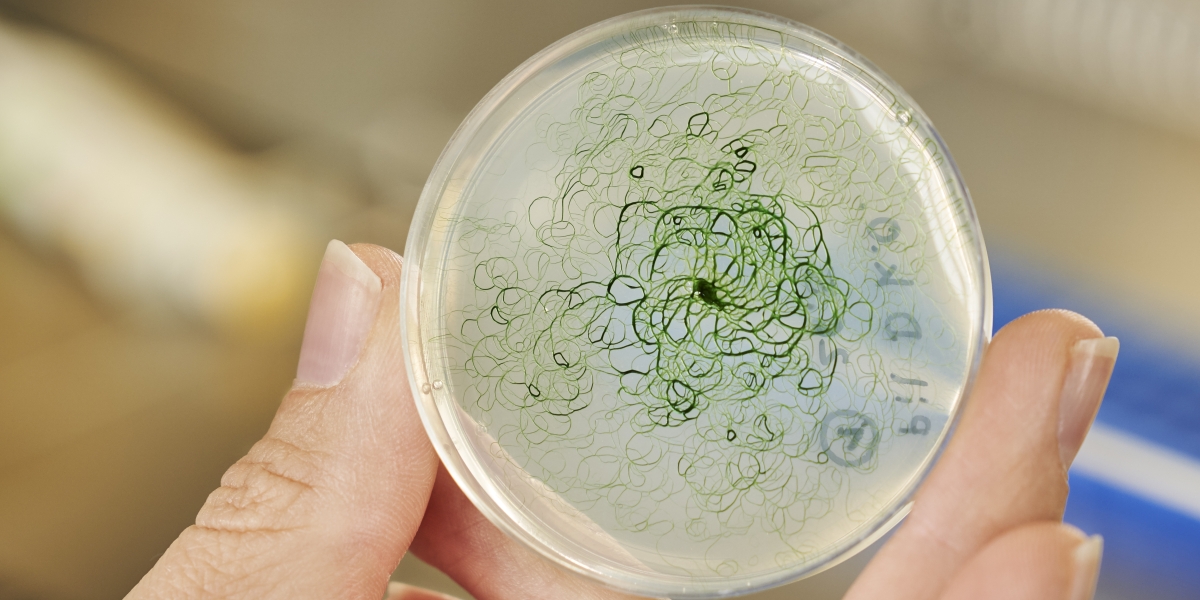

Bioökonomie
Bioökonomie ist das Thema des Wissenschaftsjahrs 2020/21. Doch was ist eigentlich Bioökonomie? Eine erste Einordnung von Expertinnen und Experten aus dem Karlsruher Institut für Technologie (KIT) finden Sie hier. Unser Dossier liefert Ihnen einen kompakten Überblick über dieses weite Themenfeld und erklärt, warum das Zukunftsversprechen Bioökonomie so wichtig ist.
Anhand von praktischen Beispielen aus der Forschung am KIT lesen, sehen und hören Sie, was Bioökonomie zu leisten im Stande ist. Der Grundgedanke der Bioökonomie ist dabei so simpel wie herausfordernd: nachhaltig leben und unseren Lebensstandard erhalten.
Einen Einstieg ins Thema bieten Christine Rösch und Dirk Scheer. Im Video erklären sie, was Bioökonomie will, welche Chancen sie bietet und welche Herausforderungen uns auf dem Weg dorthin begegnen. In der aktuellen Ausgabe des Forschungsmagazins lookKIT können Sie noch tiefer in die Welt der Bioökonomie eintauchen.
Inhalt
sprungmarken_marker_27725

Bioökonomie ist Schwerpunktthema der Ausgabe 3/2020 des Forschungsmagazins lookKIT.
Zum HeftRegenerative Kraftstoffe für das Klima
Die Initiative „reFuels – Kraftstoffe neu denken“ hat die effiziente Herstellung regenerativer Kraftstoffe zum Ziel. Diese haben dieselbe Energiedichte wie fossile Treibstoffe und sind deshalb neben anderen Maßnahmen wie dem Ausbau der Elektromobilität ein vielversprechender Weg hin zu einer CO2-neutralen Mobilität. Dieses Ziel zu erreichen, wird jedoch einige Zeit in Anspruch nehmen. Auch in den nächsten Jahren werden Fahrzeuge mit Verbrennungsmotor den Großteil der Mobilität ausmachen und auch langfristig im Langstreckenverkehr benötigt.
„Unter regenerativen Kraftstoffen fassen wir die strom- und biomassebasierten Kraftstoffe zusammen. Sie können aus CO2 gewonnen werden, das durch Biomasse in Pflanzen gebunden wurde, aber auch aus Industrieabgasen und letztendlich auch aus der Luft“, sagt Professor Jörg Sauer, einer der Projektverantwortlichen von „reFuels“.
reFuels haben verschiedenen Vorteile: Sie emittieren weniger klimaschädliches CO2 und durch ihre Weiterentwicklung wird es gelingen, die Verbrennung sauberer als mit konventionellen fossilen Kraftstoffen durchzuführen. Um die Energiewende im Verkehr möglich zu machen und weiter voranzutreiben, müsse das Potenzial reststoff- und strombasierter Kraftstoffe zusammengedacht und genutzt werden, so Sauer.
Auch beim Thema Bioökonomie spielen regenerative Kraftstoffe eine wichtige Rolle: „Unser generelles Ziel sollte sein, den durch menschliche Aktivitäten beeinflusste Kohlenstoffkreislauf zu schließen“, sagt Professor Nicolaus Dahmen, der die Kraftstoffherstellung im Projekt koordiniert. „Wir klinken unsere Prozesse in den natürlichen Kreislauf ein, indem wir das von der Biomasse aufgenommene und gebundene CO2 nutzen und bei der Verwendung der regenerativen Kraftstoffe nicht mehr CO2 erzeugen, als vorher schon da war. So können wir zusätzliche CO2-Emissionen verhindern.“
Klimafreundlicher Massivbau
„Massivbau hört sich schwer und wenig ‚grün‘ an - wir zeigen aber, wie innovativ und nachhaltig das Bauen mit Beton, Ziegeln und Mauerwerk sein kann“, sagt Frank Dehn. Der Professor für Baustoffe und Betonbau leitet die Materialprüfungs- und Forschungsanstalt Karlsruhe (MPA) und vertritt das KIT als Fachbeirat im Netzwerk solid UNIT.
Darin haben sich verschiedene Partner aus Baden-Württemberg zusammengetan, um ressourceneffizientes und CO2-einsparendes Bauen voranzutreiben. Das im Dezember 2019 als Verein gegründete Netzwerk versteht sich als Technologiedrehscheibe, die neue Erkenntnisse, Baustoffe und Bauverfahren schneller auf der Baustelle zum Einsatz kommen lassen möchte.
„Wir brauchen Lösungen dafür, wie wir mit den vorhandenen Rohstoffen effizient umgehen, um den steigenden Bedarf an Infrastruktur und im Gebäudesektor zu decken und dazu beizutragen, die weltweiten CO2-Emissionen zu senken“, sagt Dehn. Denn aktuell ist die Bauindustrie ein maßgeblicher Verursacher des menschengemachten CO2-Ausstoßes.
Der Bauingenieur und sein Team forschen vorwiegend an mineralischen Baustoffen und alternativen Herstellungsprozessen. Die Suche der Expertinnen und Experten nach klimafreundlichen Lösungen für den Bau profitiert vom Austausch im Netzwerk. „Bei solid UNIT sind alle Stakeholder zugleich am Tisch und ziehen an einem Strang, um neue Technologien und Baustoffe schnell in die Praxis zu bringen“, betont Dehn.
Einen wesentlichen Part übernimmt die MPA. „Als national anerkannte Prüf-, Überwachungs- und Zertifizierungsstelle ist die MPA ein wichtiges Instrument. Wir prüfen Baustoffe auf Herz und Nieren und bedenken alle Eventualitäten, die auf ein Bauwerk einwirken könnten“, erklärt Dehn, der eine spannende Herausforderung darin sieht, neben der Grundlagenforschung auch die Anwendung von Produkten im Auge zu haben: „Es muss nicht nur funktionieren, sondern auch am Markt durchsetzbar sein.“
CO2-fressende Bakterien
Das Forschungsprojekt „BioElectroPlast” begann 2015 mit einer Reise auf die Azoren. In den dortigen Hydrothermalquellen hoffte das Team um Professor Johannes Gescher, Leiter der Abteilung Angewandte Biologie am Institut für Angewandte Biowissenschaften (IAB), geeignete Mikroorganismen für ihr Forschungsvorhaben zu finden. Sie suchten ein Bakterium, das CO2 aus Rauchgas aufnehmen und weiterverarbeiten kann. Rauchgas fällt als klimaschädlicher Abfallstoff sowohl in Blockkraftwerken als auch in der chemischen Industrie in großen Mengen an.
Das Ziel der Forscherinnen und Forscher: Der Einsatz der hitzeliebenden Bakterien, um aus dem klimaschädlichen Gas Bioplastik herzustellen. Der Weg dorthin: Mikrobielle Elektrosynthese. Dabei wachsen Mikroorganismen auf einer Kathode, nutzen diese als alleinige Energie- und Elektronenquelle und fixieren CO2.
Nach zweijähriger Suche fand die Forschungsgruppe in den Matschproben von den Azoren ein Bakterium, das die gewünschten Kriterien erfüllte: Kyrpidia spormannii. Unter feucht-heißen Bedingungen kann es auf einer Kathodenoberfläche einen Biofilm bilden und stellt mithilfe von elektrischem Strom aus CO2-Molekülen energiereiche chemische Verbindungen her, wie zum Beispiel das Biopolymer Polyhydroxybuttersäure (PHB).
„Wenn der Biofilm dick genug ist, wird ein Teil davon durch eine Schervorrichtung von der Drehscheibe abgeschabt. Die geerntete Biomasse wird so aufbereitet, dass PHB als weißes Pulver vorliegt. Dieses können wir als Grundsubstanz zur Herstellung von Bioplastik verwenden”, erklärt Gescher. Durch Bestrahlung mit UV-Licht und anschließende Selektion isolierten die Forschenden einen angepassteren Kyrpidia spormannii-Stamm, welcher noch schneller einen Biofilm bilden kann.
In einem nächsten Schritt sollen die Parameter, die bislang für den Zehn-Liter-Reaktor optimiert worden sind, auf einen 100-Liter-Reaktor hochskaliert werden. Am Ende soll es ein standardisiertes Verfahren für die gesamte Industrie geben. Neben der Reduktion von klimaschädlichem CO2 aus industriellen Abgasen und der kosten- und ressourcenschonenden Herstellung von Bioplastik und Biokraftstoffen ermöglicht das Verfahren die Zwischenspeicherung von Energie aus regenerativen Quellen bei Produktionsspitzen in chemischer Form.
„Viele Lösungen liegen schon lange in der Schublade“ - Professor Michael Meier
Kunststoffe aus der Natur
Nachwachsende Rohstoffe wie Stärke, Cellulose oder Pflanzenöle bieten für die Herstellung von Kunststoffen großes Potenzial. Sie sind vielfältig einsetzbar und die hieraus entstehenden Produkte - Verpackungen, Textilien, Schläuche oder auch Polster für Autositze - binden große Mengen CO2. Um fossile Rohstoffe zu ersetzen, wollen Professor Michael Meier und sein Team vom Institut für Organische Chemie (IOC) des KIT diese nützlichen Polymere nach den Prinzipien der nachhaltigen Chemie für zukünftige Anwendungen weiterentwickeln.
„Rund 350 Millionen Tonnen Kunststoffe werden jährlich aus Erdöl hergestellt“, führt Meier an, um klar zu machen welche Bedeutung nachwachsende Rohstoffe für die Bioökonomie der Zukunft haben: „Kunststoffe bilden den mengenmäßig größten Output der chemischen Industrie.“ Meier und sein Team haben sich einer nachhaltigen Chemie verschrieben und dabei den gesamten Lebenszyklus eines Produktes im Blick.
Die Forschungsgruppe untersucht alle zur Verfügung stehenden nachwachsenden Rohstoffe. Diese sind vielfältig verwendbar, so wird Cellulose bei der Herstellung von Textilfasern, Lacken oder Klebstoffen eingesetzt. Stärke kann als Bindemittel oder Füllstoff dienen. Das derzeit gebräuchlichste Polymer aus nachwachsenden Rohstoffen ist Polyactid, das sich im Verpackungsbereich oder der Medizintechnik als Ersatz für petrochemisch gewonnene Rohstoffe zunehmend etabliert.
Eine gewisse Übergangszeit vorausgesetzt, sei man heute in der Lage, 90 Prozent der fossilen Rohstoffe durch nachwachsende Alternativen zu ersetzen. Aber auch wenn es viele dieser neuen Polymere bereits in die kommerzielle Anwendung geschafft haben: Erdöl bleibt nach Meiers Einschätzung immer noch deutlich zu billig. „Wenn Anwendungen scheitern, liegt es meistens am Preis“, sagt er. Mithilfe seiner Forschungsarbeit möchte der Experte für nachhaltige Chemie nachwachsende Polymere wettbewerbsfähiger machen.
Geschärfte Genschere
Die Bioökonomie kommt nicht ohne eine nachhaltige und ertragreiche Landwirtschaft aus. Um Pflanzen besser auf sich verändernde Umweltbedingungen anzupassen, können ihre Eigenschaften mit Hilfe der Genschere CRISPR/Cas gezielt kombiniert werden. Dank der Forschung am Botanischen Institut lassen sich jetzt sogar ganze Chromosomen neu zusammensetzen
Schon seit einigen Jahren arbeitet der Molekularbiologe Professor Holger Puchta am Botanischen Institut des KIT an der CRISPR/Cas-Technologie. Nun ist es ihm gelungen, die molekulare Schere scharf zu schleifen: Bisher konnte sie nur einzelne Gene austauschen. Jetzt kann sie ganze Chromosomen neu zusammensetzen.
Das bedeutet einen wesentlichen Fortschritt: Im Erbgut sind die einzelnen Gene ja in einer festgelegten Reihenfolge auf den Chromosomen angeordnet. Entscheidende Gene liegen häufig ganz nah beieinander auf demselben Chromosom und werden zusammen vererbt. Die verbesserte CRISPR/Cas-Technologie macht es möglich, viele Gene gleichzeitig von einem Chromosom auf ein anderes zu übertragen.
Gemeinsam mit Professor Andreas Houben vom Leibniz-Institut für Pflanzengenetik und Kulturpflanzenforschung (IPK) in Gatersleben hat das Team um Holger Puchta am KIT an der Modellpflanze Ackerschmalwand erstmals demonstriert, wie sich mithilfe des Proteins Cas9 Arme zwischen Chromosomen austauschen lassen. Die neu zusammengesetzten Chromosomen werden wiederum normal vererbt.
Wissenschaftlerinnen und Wissenschaftler können auf diese Weise künftig unvorteilhafte Eigenschaften von guten trennen, um so positive Merkmale zusammenzuführen. Auch komplexe Attribute wie Salz- oder Trockenresistenz, an denen mehrere Gene beteiligt sind, sollten sich damit gezielt in Kulturpflanzen einbringen lassen – (überlebens)wichtig angesichts des Klimawandels.
Reis im Stress

Eine Welt ohne Reis? Undenkbar. Das Getreide aus der Familie der Süßgräser ist eines der wichtigsten Grundnahrungsmittel der Welt. Durch die zunehmende Versalzung der Böden infolge des Klimawandels sind die Reisernten jedoch bedroht. Der Molekularbiologe Professor Peter Nick und sein Gruppenleiter Dr. Michael Riemann untersuchen daher, wie man Stressreaktionen von Reispflanzen auf den steigenden Salzgehalt abmildern kann.
Gemeinsam mit Partnern aus der ganzen Welt wie dem International Rice Research Institute (IRRI) auf den Philippinen nehmen Nick und sein Team die Gene der Pflanzen unter die Lupe: „Wir versuchen, Gene zu identifizieren, von denen wir vermuten, dass sie für eine Stresstoleranz relevant sind.“
Wie bei Menschen und Tieren treten auch in der Pflanzenwelt durch Stress Hormone auf den Plan. Unser Körper schüttet als Stressantwort Adrenalin aus, Pflanzen bilden Jasmonsäure. Die Forscherinnen und Forscher fanden heraus, dass der Reis gegenüber dem Salzstress toleranter ist, wenn der Signalweg der Jasmonsäure rechtzeitig abgeschaltet wird. „Wenn wir in der Lage sind, das An- und Abschalten des Signalwegs zu steuern, können wir das Hormon so manipulieren, dass es vom Rezeptor der Pflanze nicht mehr erkannt wird“, sagt Nick. „In Zukunft könnte es dadurch möglich werden, Reis auch unter Stress zur Erzeugung von Ertrag zu bringen.“
So könnte Bioökonomie einen Beitrag dazu leisten, die Lebensmittelversorgung der Weltbevölkerung sicherzustellen.